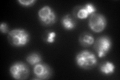
YHR039C-A
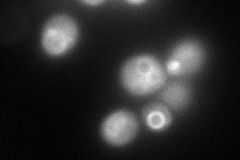
YHR039C-A
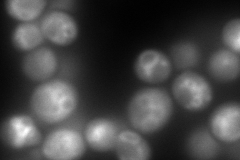
YHR039C-A
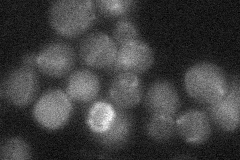
YHR039C-A
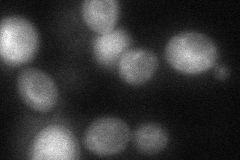
YHR039C-A

View description
Subunit G of the eight-subunit V1 peripheral membrane domain of the vacuolar H+-ATPase (V-ATPase), an electrogenic proton pump found throughout the endomembrane system; involved in vacuolar acidification
Localization:
Intensity:
Fold change:
Significance:
-
C’ GFP library in SD
vacuole membrane233.11 -
N' NOP1pr-GFP in SD
vacuole membrane20.5578 -
N' TEF2pr-mCherry in SD
vacuole membrane382.183 -
N' NATIVEpr-GFP in SD
below threshold17.4036 -
N' TEF2pr-VC and Cyto-VN in SD
below threshold23.0656 -
C’ GFP library in SD+DTT

vacuole membrane294.821.26No -
C’ GFP library in SD+H2O2

vacuole membrane193.950.83No -
C’ GFP library in Starvation Media

vacuole membrane503.12.15Yes -
C’ GFP library on the background of Pup2-DaMP

vacuole membrane -
C’ GFP library on the background of CCT mutant

vacuole membrane128.2590.550187Yes
